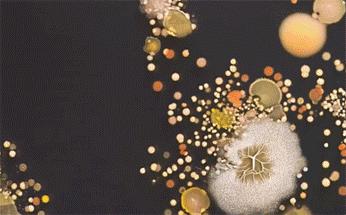
暑假孩子玩手机不如打篮球吧,儿童显微镜放大蚂蚁120倍

40X倍的显微镜下:
看似清澈的鱼缸水里,此刻正有一只水熊虫恰巧路过。
对,没错,就是那个不怕冷、不怕热,不怕真空不怕辐射,号称 地表Zui强生物的水熊虫。

200X的显微镜下:
如果你出去玩, 碰巧有一片水看起来绿绿的低洼,那恭喜你,可以捡到草履虫了。
装一小瓶水回家,如果在显微镜下观察的大草履虫是活的,就会发现它们不是一个科学书上的扁片,而是立体的。
在水中依靠体表纤毛有节奏地摆动,旋转着向前游动;如果撞上障碍物还会反向摆动纤毛,先挂倒挡再换方向。

300X的显微镜下:
一滴污水居然也有个“小世界”。
难怪老人总会说, 佛观一钵水,八万四千虫,喝水一定要烧开了才更健康。

400X的显微镜下:
用胶布在脸上粘一夜,第二天撕下来,你就可以获得一只白白胖胖的“大螨虫”。
看来平时要更注意除螨和清洁了。

如果没有显微镜,可能真的不会发现我们生活的周围,以及我们的身上,原来还存在着这样一个神奇的世界。
不仅是我们, 生物学家们也是通过显微镜,才能进入“另一个世界”:

实时观察到生物分子如何在大脑神经细胞之间生成神经突触,看到病毒颗粒侵入细胞的全过程。
甚至还可 追踪帕金森、阿尔兹海默症、亨廷顿症患者 体内相关蛋白的累积过程

图源网络:细胞分布及蛋白质距离
科学家们也会利用显微镜,让一系列人类肉眼无法看到的致命病菌暴露出庐山真面目。

在今年的三胎计划颁布后,早前科学家们利用显微镜研发的“精子助推器”,又一次成为了热议。
因为如果真的成功,就能 让你从受精卵开始提前开挂,走上“人生巅峰”。

不过在我们大家的眼中,显微镜,这种高科技物件,只有在生物课上才能看见的稀罕玩意儿。似乎却是很多年没再拿起过了。
而且那时候那时候也还没现在这么便捷, 都是那种又大又笨重的,只能固定在实验台上,操作起来也很麻烦。
大家都是排队轮流去观察洋葱细胞、叶子纹路,资源也没有富裕到能人手一台,当然了想买也买不起。

诺贝尔奖获得者大隅良典,说过: 显微镜可以让孩子从小养成探索世界的兴趣,对孩子成长尤为重要。这也是为什么越来越多的教育,会更重视显微镜。
因为只有见过大自然之奇妙的孩子,视野才会更宽广,求知欲更强、会观察、善表达。
“幼年时通过接触大自然,萌生出最初的探知兴趣和欲望,是通往一代科学巨匠的道路。”

所以家里备上一个小巧便携操作又方便的显微镜,还是很有大用处的。
但大部分的便携式显微镜,都得眯着眼,凑近小的可怜的目镜上,才能在夹缝中欣赏到另一个美丽世界,真的非常难受。
眼睛不自觉会会处于紧绷的状态,稍微看会儿就容易眼疲劳,甚至有点头昏脑涨,需要看远处放松一下。

而最近,发现了一个宝藏显微镜—— 「当当狸显微镜」

完全不用再盯着单目镜头眯眼看,而是 可以通过APP无线连接。

直接将整个微观世界搬上了你的手机。

甚至是电脑屏幕、平板屏幕上,都可以。

调节好观察焦距后,就可以得到 400X的专业光学放大效果 ,平时观察绝对够用了,成像也足够清晰。

小小一支还没手机大,就像是一个可以 随时放进口袋里的小玩具。

当当狸实拍
任何东西放到下面,都会打破我们对它们的既有印象:
抓一只这个季节最讨人厌的 蚊子 来看看。

当当狸实拍
没想到身上居然会有这么多的绒毛和倒刺?

当当狸实拍
仔细看,还能观察到清晰的呼吸,鸡皮疙瘩都快起来了......

当当狸实拍
随处可见的 小蚂蚁 ,眼睛放大后居然还会有充满科技感的排列细胞,简直太神奇了。

图源:当当狸品牌方提供
和影视剧《蚁人》里的蚂蚁形象,简直相差无几。

图源网络
路边的 泥土 ,在显微镜下,更像一个无数沙砾组成的沙漠。


当当狸实拍
随便找了一片掉落在灌木丛边上的 叶子 ,拿过来观察观察。
原本看似平整的叶面上,居然有着这么多的千沟万壑和各种错综复杂的纹路。

当当狸实拍
一千片叶子就有一千种模样,那么我们脑袋上的 头发 呢?表面上看起来大差不差,用显微镜看看呢,又会是什么效果?

模特实拍
问了一圈后才找到的从未烫染的健康秀发: 黝黑结实,中间呈实心状态

当当狸手机实拍
经常烫染的粗糙沙发: 边缘断裂,中间呈空心状态


当当狸手机实拍
分叉的毛糙发质: 可以看到马上长出分叉的结节,以及杂草般的分叉


当当狸手机实拍
甚至还能用它来 检测皮肤状态 ,护肤品有没有效果,粉底液哪个更好用,放大后清楚直接明了,太赞了!

当当狸实拍
操作起来也是相当简单,APP上一键拍照、录像 ,就能把你看到的精彩画面保存下来,慢慢观察.....

当当狸APP截图
更有意思的是,不仅可以手持随时观察想看的任何东西外, 还能安上配套的底座,变身更专业的台式显微镜。
既可以是打开孩子微观世界大门的钥匙,让孩子变身 “小小生物学家”。

图源:当当狸品牌方提供
还可以用显微镜让孩子亲眼看看,原来还存在细菌、脏东西、残留物和看不见的微生物, 自然便知道要勤洗手讲卫生。
图源网络
也可以是大人鉴赏各种珠宝的神器,珠宝的通透质地和细节在显微镜的自带灯光下,熠熠生辉, 用起来可不比赏玩工具差。

当当狸手机实拍
用来 检验精密的手表零部件、男生的玩具模型,也都很清晰。

当当狸手机实拍
除了显微镜本身之外,其他配件也是一大亮点:
打开套装的箱子,瞬间就会感觉收获满满超级值,个人真的强烈建议将整个套装都收入囊下,已经剁手了!

当当狸实拍
除了显微镜本身之外,还有10片生物载玻片标本,以及标本采集和制作的各种工具包, 一应俱全。


当当狸实拍
而且还有更多想买都买不到的 超值赠品 ,真的感觉赚翻了!

当当狸实拍
更贴心的是,显微镜采用了ABS材质作为机身,手感舒服,机身圆润,孩子玩起来也不容易受伤。

图源:当当狸品牌方提供
而且不仅经得起折腾,还通过了多项安全检测,更可以放心玩。

图源:当当狸品牌方提供
最关键的是,这次还为大家争取到了两款规格的粉丝福利价: 显微镜单镜+超值大套装
可以单独购买单镜,给家里的孩子涨知识,毕竟大自然的玩具不像商业玩具被赋予了特定的意义,它更能发挥孩子的想象力,语言描绘能力。

当当狸实拍
也可以购买套装款式,美观又实用,即能是孩子的“好伙伴”,又能是我们的小助手,不管是自己把玩还是送给朋友,都非常适合。

当当狸实拍
早在2个月之前,我们就和当当狸的品牌方开始了“价格战”。
终于在上架前,给大家搞来了超低价,指导价399, 而现在推文价299就能买到了,499直接就是一个大套装,真“性价比天花板”了!

当当狸实拍


显微镜真的是个很神奇的存在,任何东西放到它的下面,都总会展现出我们不熟悉的「另一面」:
放大后的巧克力 ,感觉自己看到了月球表面。

图源网络
我们平时经常吃的 盐 ,看起来就是普普通通的白色晶状体,非常的平平无奇。

图源网络
但换一种角度,却好像来到了 月球表面。

图源网络
再来看看盐结晶的画面, 美的就像是水墨画。

图源网络
为什么总说 西兰花 不好清洗?

图
看看显微镜下西兰花的吧,你就知道它长得有多密集了, 有多少缝隙可以藏污纳垢 了。

图源网络
再放大点,表面的灰尘都能看得一清二楚。

图源网络
经常喝的 咖啡 ,居然是呈现火山岩石的形态,红彤彤的颜色,凑近看都觉得有一股灼烧感。

图源网络
如果拉远点看,给它加点水呢?

图源网络
看着它慢慢被溶解的样子,感觉真的太治愈了!

图源网络
喜欢听古典音乐的朋友,家里总有一个 黑胶唱片机 ,那你想没想过它发声状态下是什么样子呢?

图源网络
放大后的针头看起来就像一支铅笔在不平整的凹槽里画着各种各样的轨迹,这些 微小的摩擦被放大之后就变成了动听的音乐。

图源网络
显微镜打开的这扇“微观世界大门”,就像黑洞一样吸引我们,想要随时进入。

图源网络
自从有了当当狸的显微镜,几乎每天都揣在兜里装在包里,想看的时候随时拿出来看看。

当当狸实拍
横切的南瓜茎,看起来就像杨桃,难怪吃起来甜甜的。

当当狸实拍
百合的子房,居然还能看到未发育的胚芽。

当当狸实拍
蜜蜂前足上有这么多可爱的小绒毛,怪不得它是传播花粉小能手。

当当狸实拍
孔雀的羽毛和兔子的毛发,都在有序排列着。


当当狸实拍
横切的松叶像镶嵌了宝石的扇子,有点好看。

当当狸实拍
还用它看了看金鱼的鳞片、蚂蚁的脑袋、牛皮纸袋、纤维面料,还有电脑屏幕,想看什么就看什么。
01

02

03

04

05

当当狸实拍
而且它够小够轻,拿在手上还没有巴掌大, 重量还不到100g。

当当狸实拍
比手机还要小很多,随身带着根本毫无负担感。

当当狸实拍
别看它小,但 成像能力却足够清晰 ,和市面上大部分只能放到到60-120倍的便携显微镜相比,它更专业。
可以放大到100倍-400倍 ,日常不管是孩子学习,还是大人把玩鉴赏,都完全够用了。

当当狸实拍
傻瓜式操作,小孩子也能快速上手, 长摁中间摁钮3秒即可开机。

当当狸实拍
在你的手机、平板、电脑上*载下**好当当狸显微镜,就能无线闪连。

当当狸实拍
然后转动底部变倍环,就能调整到清晰的倍率,开始观察了。

当当狸实拍
在APP页面上, 一键就能智能拍照、录像,记录你看到的画面。

当当狸实拍
昏暗的环境担心成像模糊?不存在的,这个显微镜 自带8颗LED灯。
不分白天黑夜,兴致来了随时都可以拿出来观察一番。

当当狸实拍
拿起单体显微镜,放在底座上, 还能秒变专业台式显微镜。

当当狸实拍
旋转侧边旋扭,即可升降调节显微镜镜头的位置。

当当狸实拍
底座是磁吸式设计,可以自动吸附标本。

当当狸实拍
装夹起来超级方便。

当当狸实拍
扭一扭就能自动对焦,然后还能操作单体镜上的摁钮, 放大缩小 。

当当狸实拍
不想用现成的标本自己做标本不会染色?还可以直接省掉这一步。

当当狸实拍
直接转动底座左侧并排的两个摁钮,就可以按成像效果, 选择适合观察的颜色。

当当狸实拍
不用的时候也不用担心会进灰尘,随手套上 防尘罩 就可以了。

当当狸实拍
两种模式可以随时切换,手持单体镜走哪儿就能观察到哪儿,安上底座,还能更专业地观察细胞结构。
在抽象的微观细胞世界里,可以尽情地发挥自己的想象。
不仅是孩子打开微观世界大门的钥匙,也是大人鉴赏珠宝的神器,可以说是物所超值了。

当当狸实拍
除了显微镜本身之外,其他配件也是一大亮点:
里面十分难得赠送了10片生物载玻片(标本):孔雀的羽毛、玉米的胚芽、小肠的切片……
从植物组织切片到动物皮毛细节,应有尽有。

当当狸实拍
现成的载玻片如果不能满足你, 还可以自己采集标本制作生物标本 ,整个过程真的可太有意思了!

当当狸实拍
打开配件盒, 里面还有标本采集以及制作的工具包,一应俱全。

当当狸实拍
而且还有更超值的赠品,想单独买还买不到的那种:
l 附赠科普绘本(非卖品)——用原创插画展示微观世界


当当狸套装配件实拍
随处可见的小昆虫们,竟然有不同的腿部结构,明明都是须须的触角长得也不一样:

当当狸套装配件实拍
吃起来酸甜可口的食物,显微镜下的它们却可能存在着很多对健康的“威胁”。

当当狸套装配件实拍
原来,显微镜还能被用在刑侦手段上帮警察更快地抓到罪犯,检测指纹。

当当狸套装配件实拍
l 专属记录册(送贴纸)——写下每一次的观察日记

当当狸套装配件实拍
科学探索变得更有仪式感,这样还能 让孩子培养出观察记录的好习惯。


当当狸套装配件实拍
l 免费视频教程,帮助孩子解锁更多趣味性玩法。

当当狸详情页截图
可以单独购买单镜,给家里的孩子涨知识,毕竟大自然的玩具不像商业玩具被赋予了特定的意义,它更能发挥孩子的想象力,语言描绘能力。

当当狸实拍
也可以购买套装款式,美观又实用,即能是孩子的“好伙伴”,又能是我们的小助手,不管是自己把玩还是送给朋友,都非常适合。

当当狸实拍
最重要的是,还帮大家争取到了抄底价:
早在2个月之前,我们就开始和当当狸的品牌方开始了“价格战”。
终于在上架前,给大家搞来了超低价,指导价399, 而现在推文价299就能买到了,499直接就是一个大套装,真“性价比天花板”了!

当当狸实拍
「当当狸智能显微镜」
(大人、小孩皆宜)
400X专业光学倍数成像超清晰
单镜可把玩还能秒变台式显微镜
当当狸智能显微镜DDLM1,便携手持电子高倍多功能学生实验放大镜
¥399
购买